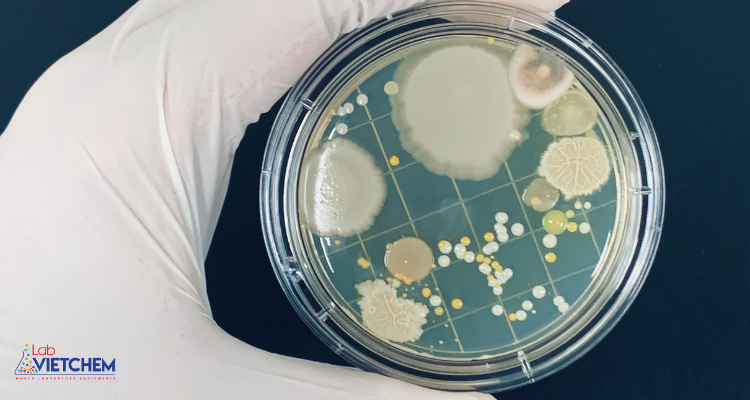
Môi trường nuôi cấy vi sinh vật là gì?
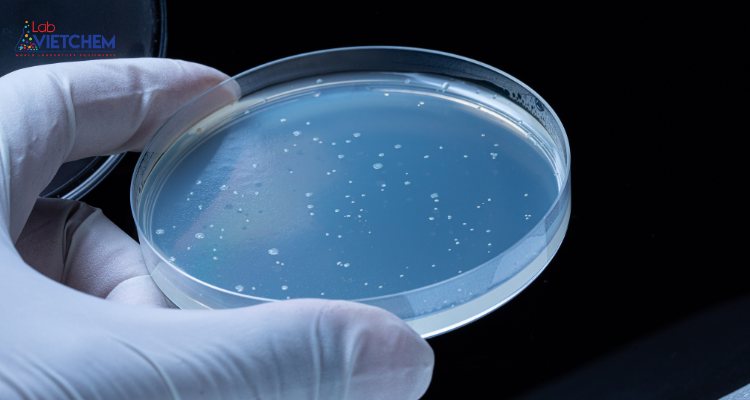
thạch thạch

Nội dung bài viết
Tại sao phải nuôi cấy vi sinh vật? Môi trường nuôi cấy vi khuẩn, virus như thế nào? Hãy cùng tìm hiểu qua bài viết dưới đây để hiểu rõ hơn về môi trường nuôi cấy vi sinh vật.
1. Môi trường nuôi cấy vi sinh vật là gì?
Nuôi cấy là việc đưa vi sinh vật vào vật chứa chứa môi trường dinh dưỡng vô trùng. Khi nuôi cấy vi sinh vật trên môi trường đặc có agar, quá trình lấy mẫu sẽ được thực hiện bằng que nuôi cấy có vòng kim loại ở đầu được khử trùng nhanh bằng cách đun nóng trên đèn cồn. Thông thường, thao tác này sẽ được thực hiện trong tủ vô trùng để giảm thiểu nguy cơ ô nhiễm. Điều quan trọng trong quá trình nuôi cấy là nắm vững kỹ thuật pipet phù hợp để nhận và lấy mẫu.
Môi trường nuôi cấy vi sinh vật là môi trường chứa nhiều chất dinh dưỡng khác nhau, cần thiết cho sự sinh trưởng và phát triển của vi sinh vật.
Môi trường nuôi cấy vi sinh vật là gì?
2. Có một số loại môi trường nuôi cấy vi sinh vật
Có nhiều cách khác nhau để phân loại môi trường vi sinh vật. Dựa vào nguồn gốc và thành phần các chất dinh dưỡng, người ta có thể chia làm 3 loại chính:
– Môi trường sử dụng các chất tự nhiên: Chứa các chất tự nhiên như chiết xuất thịt bò, chiết xuất men bia,…
– Môi trường tổng hợp: Chứa các chất đã biết thành phần hóa học và số lượng. Chẳng hạn như môi trường chứa glucose và axit amin.
– Môi trường bán tổng hợp: Là sự kết hợp của 2 loại trên chứa cả chất tự nhiên và hóa chất. Ví dụ: Môi trường chứa peptone, chiết xuất thịt và một lượng axit amin và glucose nhất định.
>> Xem thêm: Phân loại và ứng dụng vi sinh vật trong thực tế.
3. Công thức môi trường nuôi cấy vi sinh là gì?
Để tạo môi trường nuôi cấy vi khuẩn, nấm sẽ là sự kết hợp của nhiều thành phần phù hợp với sự phát triển của từng đối tượng. Thông thường sẽ có 7 nhóm nguyên liệu với các giá trị khác nhau:
3.1. Nhà cung cấp dinh dưỡng
Nhóm này thường cung cấp các thành phần như protein, axit amin và peptide. Đây đều là những yếu tố tăng trưởng cần thiết cho môi trường nuôi cấy vi sinh vật.
Chiết xuất từ thịt (thịt chiết xuất) chứa các phần protein hòa tan trong nước (axit amin và peptide) và cũng chứa các nguyên tố khác như vitamin, kim loại vi lượng, khoáng chất và carbohydrate (glycogen). Thông thường phương pháp chiết xuất này dẫn đến hàm lượng nitơ axit amin thấp, không đảm bảo sự phát triển của số lượng lớn vi khuẩn. Đó là lý do tại sao nhiều môi trường sử dụng chất chiết xuất từ thịt và protein thủy phân.
Sản xuất dung dịch đạm rất khó khăn nên thị trường chủ yếu được sản xuất và tiêu thụ ở dạng khô.
3.2. Chất cung cấp năng lượng
Ngoài các chất cần thiết cho sự phát triển của vi sinh vật, chất cung cấp năng lượng là một trong những yếu tố quan trọng làm tăng tốc độ phát triển của vi khuẩn. Nguồn năng lượng chính là glucose, các hợp chất carbohydrate khác như lactose hoặc L-arabinose cũng được sử dụng.
Carbohydrate được thêm vào môi trường ở mức 5-10 g/l, với sự có mặt của cơ chất sinh hóa để xác định sự sản sinh enzyme trong nhận dạng sinh vật. Vì vậy, chất chỉ thị thường được bổ sung vào môi trường nuôi cấy vi sinh vật.
3.3. Kim loại và khoáng chất thiết yếu
Để đảm bảo sự phát triển và sinh trưởng bình thường của vi sinh vật, cần bổ sung các thành phần vô cơ cần thiết vào môi trường nuôi cấy, bao gồm:
– Thành phần có nồng độ lớn (g/l): Na, K, Cl, P, S, Ca, Mg, Fe.
– Thành phần với lượng nhỏ (mcg/l): Zn, Mn, Br, B, Cu, Co, Mo, V, Sr…
3.4. Hệ thống đệm
Mỗi loại vi sinh vật sẽ luôn có một môi trường lý tưởng thích hợp cho sự sinh trưởng và phát triển. Vì vậy, việc sử dụng các hợp chất đệm để cân bằng pH là cần thiết khi bổ sung carbohydrate lên men vào môi trường làm nguồn năng lượng.
Các chất được thêm vào môi trường chủ yếu là photphat, axetat, citrat, ion lưỡng tính và một số axit amin đặc biệt khác. Tuy nhiên, nó có nhược điểm là có thể bắt giữ các ion hóa trị hai để tạo thành các phức chất như Ca++ và Mg++. Chúng ta có thể quan sát độ đục trong môi trường nuôi cấy sau khi đun nóng hoặc giữ ở nhiệt độ 50 độ C do sự tương tác giữa phốt phát và kim loại. Vì vậy làm giảm lượng kim loại thiết yếu trong môi trường này, đặc biệt là Fe.
3.5. Chỉ số
Chỉ thị màu giúp phát hiện hiệu quả màu sắc lên men của các loại carbohydrate cụ thể trong môi trường nuôi cấy. Chất này chuyển sang màu khác nhau tùy theo sự thay đổi độ pH.
Có nhiều hợp chất màu như: đỏ phenol, tím bromocresol, fuchsin…

Chỉ tiêu trong nuôi cấy vi sinh vật
3.6. Tác nhân chọn lọc
Môi trường nuôi cấy được bổ sung hóa chất hoặc kháng sinh để sàng lọc các vi sinh vật cần xác định. Tùy theo từng loại vi sinh vật mà hóa chất sẽ được lựa chọn ở nồng độ thích hợp để ức chế sự phát triển của các vi sinh vật không mong muốn. Một số hóa chất thường được sử dụng để lựa chọn bao gồm: Muối mật, thuốc nhuộm, selenite, tetrathionate, Tellurite và azide… Một số hợp chất kháng sinh cũng được sử dụng để ức chế vi khuẩn đường ruột gây ô nhiễm mẫu. Thuốc kháng sinh sẽ có đặc tính đặc hiệu hơn các chất chọn lọc hóa học nêu trên nhưng có trọng lượng nhẹ và khả năng chịu nhiệt kém nên cần hết sức thận trọng khi sử dụng.
3.7. Chất làm cứng hoặc tạo gel
Để đông lạnh môi trường nuôi cấy người ta thường sử dụng agar agar làm môi trường nuôi cấy. Nhưng trong một số trường hợp đặc biệt người ta sử dụng gelatin và carrageenan, alginate, silica gel và polyacrylamide,…
Agar agar được sử dụng rộng rãi vì nó trơ với hoạt động của vi sinh vật, có nhiệt độ nóng chảy 84 độ C và độ bền gel cao. Ngoài ra, nó có độc tính thấp, thích hợp để phân lập vi khuẩn ưa nhiệt.
thạch thạch
Ngoài ra, tùy theo mục đích cụ thể, có thể bổ sung thêm nhiều chất làm se khác vào môi trường nuôi cấy. Ví dụ, bổ sung chất tăng trưởng cho sinh vật khó phát triển hoặc hợp chất khử eH cho sinh vật kỵ khí, v.v.
Tất cả những gì về môi trường nuôi cấy vi sinh vật? Phân loại và xây dựng môi trường nuôi cấy. Nếu bạn có nhu cầu mua đĩa peptri, agar agar, que cấy để nuôi cấy vi sinh vật hãy liên hệ ngay với LabVIEMCHEM qua hotline 0826 020 020 để đặt hàng ngay nhé!


Nội dung được phát triển bởi đội ngũ truongchuvananhue.edu.vn với mục đích chia sẻ và tăng trải nghiệm khách hàng. Mọi ý kiến đóng góp xin vui lòng liên hệ tổng đài chăm sóc: 1900 0000 hoặc email: hotro@truongchuvananhue.edu.vn